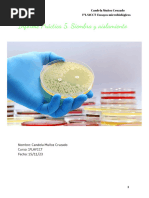

0% encontró este documento útil (0 votos)
316 vistas26 páginasPractica N°3 Microbiologia y Parasitologia
Este documento describe diferentes técnicas de siembra para el aislamiento de microorganismos, así como los efectos de agentes físicos y químicos en el control de microorganismos. Explica métodos como la siembra en placas, tubos y medios líquidos, y el uso de la autoclave, luz ultravioleta y otros agentes para eliminar microbios.
Cargado por
Giuwer Mamani CasasDerechos de autor
© © All Rights Reserved
Nos tomamos en serio los derechos de los contenidos. Si sospechas que se trata de tu contenido, reclámalo aquí.
Formatos disponibles
Descarga como DOCX, PDF, TXT o lee en línea desde Scribd
0% encontró este documento útil (0 votos)
316 vistas26 páginasPractica N°3 Microbiologia y Parasitologia
Este documento describe diferentes técnicas de siembra para el aislamiento de microorganismos, así como los efectos de agentes físicos y químicos en el control de microorganismos. Explica métodos como la siembra en placas, tubos y medios líquidos, y el uso de la autoclave, luz ultravioleta y otros agentes para eliminar microbios.
Cargado por
Giuwer Mamani CasasDerechos de autor
© © All Rights Reserved
Nos tomamos en serio los derechos de los contenidos. Si sospechas que se trata de tu contenido, reclámalo aquí.
Formatos disponibles
Descarga como DOCX, PDF, TXT o lee en línea desde Scribd